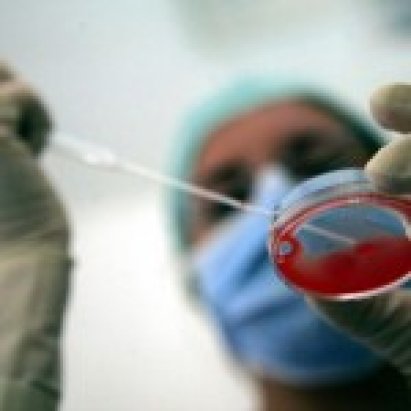
Fecondazione eterologa. Pronto per l’esame del Consiglio dei Ministri il Dpr di recepimento della normativa europea

ARCHIVIO NEWS
Tumore ovaio. Aiom: “Le morti calano del 3% negli ultimi 2 anni. Ma in Italia solo il 65% delle donne esegue il test genetico”
8 marzo 2019 - Nel nostro Paese, nel 2018, 5.200 casi. Gli inibitori di Parp sono efficaci nel controllare la malattia in fase avanzata. Fabrizio Nicolis, presidente Fondazione Aiom: “Tutte le pazienti devono essere sottoposte all’esame per verificare la mutazione Brca. Troppe le differenze regionali. E gli strumenti di prevenzione siano estesi ai familiari”. [...]
Insediato il nuovo Consiglio superiore di sanità. Franco Locatelli è il nuovo presidente. Vicepresidenti Paolo Vineis e Paola Di Giulio. Tutti gli altri incarichi
1 marzo 2019 - L’elezione è avvenuta il 22 febbraio scorso durante l’insediamento del nuovo Css. Locatelli, 59 anni di Bergamo è primario del dipartimento di oncoematologia e terapia cellulare e genica del Bambino Gesù di Roma. Vicepresidenti sono stati eletti Paolo Vineis e Paola Di Giulio. Grillo: “È l’inizio di una felice collaborazione”. Locatelli: “Metterò al servizio di questa fondamentale istituzione tutte le mie capacità e la mia più incondizionata disponibilità a lavorare nel miglior interesse del Paese". [...]
Papilloma virus. Censis: “Cresce conoscenza vaccino tra i genitori, ma ancora pochi sono consapevoli di tutti i rischi del virus”
8 marzo 2019 - Nuovo Rapporto Censis sul Papillomavirus: le patologie tumorali Hpv correlate uccidono ancora circa mille donne all’anno, ma esistono efficaci strategie di prevenzione. Aumentano i genitori che conoscono il Papillomavirus (l’88,3%). L’86,7% sa che è responsabile del tumore al collo dell’utero, ma solo il 50,3% sa che può causare altri tumori nelle donne e negli uomini. [...]
Differenza di genere nel tasso di occupazione nell’Ue: Italia (quasi) fanalino di coda
8 marzo 2019 - In Europa nel 2017, secondo gli ultimi dati elaborati da Eurostat, il tasso di occupazione delle donne tra i 20 e i 64 anni (66,5%) era dell’11,5% inferiore a quello degli uomini tra i 20 e i 64 anni (78,0%): il maggior divario è stato osservato a Malta (24,1%), seguita da Italia (19,8%) e Grecia (19,7%). [...]
UE. Nel 2018 le donne al Governo superano gli uomini in Spagna e Svezia e in media sono il 30%. In Italia quota “rosa” ferma al 16,7%
8 marzo 2019 - In ogni caso la presenza maschile resta ancora predominate sia al Governo che in Parlamento. Solo la Svezia si avvicina alla parità negli organi parlamentari con il 47% di donne elette in Parlamento. Va meglio nei Governi dove, sempre in Svezia ma anche in Spagna, le donne hanno fatto il sorpasso con il 52% di membri del Governo di sesso femminile, seguite da Francia (49%), Paesi Bassi (42%) e Danimarca (41%). L'Italia sta nella media per il Parlamento ma molto in basso come presenza di donne nell'Esecutivo. [...]
8 marzo. Fnomceo: “Le donne medico sono il 44%, ma tra gli under 40 sono oltre il 60%
8 marzo 2019 - Sono questi i numeri di genere comunicati dalla Federazione degli ordini dei medici. Anelli: “È necessario che anche i sistemi organizzativi tengano conto di questa nuova fotografia della popolazione medica e odontoiatrica, e vi si adeguino”. [...]
Oms: le donne sono il 70% in sanità ma solo una su quattro ha la leadership
8 marzo 2019 - L'attuazione di accordi di lavoro flessibili, la fornitura di programmi di tutoraggio e l'istituzione di politiche specifiche sulla discriminazione e le molestie di genere, insieme allo sviluppo della formazione di genere possono abbattere le barriere che tuttora frenano la carriera delle donne in sanità. Ma non basta. Secondo l'Oms bisogna innovare la stessa organizzazione del lavoro in sanità a partire dai criteri di progressione di carriera perché troppo spesso le donne devono concorrere in un sistema progettato per gli uomini. [...]
Buon 8 marzo a tutte e a tutti!
8 marzo 2019 - “L’affermazione di Ruskin che le donne sono migliori degli uomini è un fatuo complimento che deve provocare in loro un amaro sorriso, giacché non si dà altra situazione nella società nella quale si accetti che il migliore debba essere soggetto al peggiore.” (Rita Levi Montalcini). [...]
Cassazione. Senza consenso informato (anche prima che fosse regolamentato dalle norme) il paziente va sempre risarcito
15 marzo 2019 - Il principio vale, secondo l'ordinanza della Cassazione 6449/2019, anche se l'operazione è stata eseguita correttamente. Per la Corte l'assenza di consenso informato determina responsabilità medica anche in mancanza di previsioni specifiche. [...]
Vaccini, dopo l’obbligo aumentano le coperture e 13 Regioni superano la soglia del 95% per l’esavalente. In salita anche l’anti morbillo. Bolzano maglia nera, Lazio al top
15 marzo 2019 - Pubblicato dal ministero della Salute l’ultimo aggiornamento al 30 giugno 2018. Per la coorte di nascita 2015 il vaccino esavalente ha raggiunto in media la soglia del 95% (nello specifico sono 13 regioni sopra il target) mentre per morbillo, parotite e rosolia siamo al 94%. Crescono le coperture anche per le coorti del 2014 e per quelle del 2010. La Pa di Bolzano maglia nera mentre il Lazio è la regione con la copertura più elevata. [...]
Fertilità maschile. Scoperto in Italia il ruolo chiave di una molecola
15 marzo 2019 - La ricerca, condotta dai ricercatori del Policlinico A. Gemelli Irccs e Università Cattolica, ha evidenziato il ruolo della proteina Sam68 sui processi di maturazione dello spermatozoi. Infatti i topolini in cui il gene per la proteina Sam68 era stato messo KO non riuscivano a produrre spermatozoi maturi. [...]
L’appello degli scienziati su Nature: “Stop alla sperimentazione clinica dell’editing genetico su gameti ed embrioni umani”
15 marzo 2019 - Chiesta una moratoria che blocchi qualsiasi sperimentazione per almeno 5 anni. L'appello rappresenta di fatto la reazione all'annuncio della nascita presso lo Home Women’s and Children’s Hospital di Shenzhen (Cina) di due bambine definite “su misura” dai mass media, resistenti all’Hiv. [...]
Neonati in Tin. Migliori risultati se c’è un buon rapporto tra équipe e genitori
15 marzo 2019 - Un team israeliano ha condotto un esperimento che ha coinvolto 43 gruppi di Unità intensiva neonatale. Laddove i team erano supportati dall’empatia dei genitori si sono registrate performance sanitarie migliori. In particolare, la gratitudine materna ha avuto maggior impatto sul team di terapia intensiva. [...]
Tumore mammella HER2 positivo: promettenti i risultati del vaccino
15 marzo 2019 - Clinical Cancer Research pubblica i risultati di uno studio di fase 1 su un vaccino anti-HER2; si tratta di uno studio traslazionale, che ha coinvolto 22 donne, che arriva dopo i risultati positivi ottenuti sugli studi su modello animale. I suoi risultati suggeriscono nuove possibilità terapeutiche in questa forma di tumore della mammella che purtroppo può sviluppare resistenza ai farmaci anti-HER2. Le speranze di trattamento potrebbero dunque essere affidate ad una strategia innovativa di immunoterapia combinata: vaccino anti-HER2 e farmaci anti-PD1. [...]
Mortalità materna. In Italia 9 casi su 100mila nati vivi. Ma quasi la metà si potrebbero comunque evitare. Ecco il primo rapporto sulla sorveglianza ostetrica dell’Iss
15 marzo 2019 - Il nostro Paese è tra quelli con le performance migliori in Europa ma il 45,5% dei decessi segnalati dalla sorveglianza attiva e sottoposti a revisione critica è stato giudicato comunque evitabile con una migliore assistenza, soprattutto al Sud. Tra le cause principali di morte per cause ostetriche l’emorragia, tra quelle dovute a cause non ostetriche le patologie cardiovascolari e la sepsi. [...]
Maxi indagine su 14mila neo mamme: il 95% promuove i ginecologi e il 90% consiglierebbe lo stesso reparto ad un’amica. Smentiti gli allarmi di una precedente inchiesta che aveva parlato di “violenza ostetrica” e assistenza inadeguata
15 marzo 2019 - Questo l'esito di un'indagine condotta da Aogoi, Sigo e Agui, le tre società scientifiche italiane dei ginecologi, sul parere delle donne italiane che hanno partorito in un ampio campione di punti nascita italiani. "Questo studio - sottolineano gli autori - è a nostra conoscenza il più vasto studio condotto in un paese dell'Europa meridionale sull'esperienza di nascita della donna in ospedale". Le donne italiane sono generalmente soddisfatte della loro esperienza di nascita, ma l'informazione e il controllo del dolore devono essere migliorati soprattutto in caso di parto “complicato”. [...]
IN RICORDO DI ROBERTO SPOSETTI
La scomparsa improvvisa del Prof, Roberto Sposetti, già Primario Ginecologo dell'Ospedale S. Bortolo di Vicenza, al di là del dolore che ha colpito, oltre che la Sua Famiglia, l'intera Comunità vicentina, non può esimerci dal ricordare il contributo fondamentale che Egli ha dato con la Sua lunga attività professionale, al prestigio della disciplina ginecologica. [...]
EMILIO IMPARATO CI HA LASCIATO!
Grande perdita nel mondo della ginecologia Italiana. Il 22 marzo si è spento a Pavia il professor Emilio Imparato, un grande ginecologo, un galantuomo d’altri tempi.
La sua bonomia, il gusto della battuta, il piacere della conversazione amicale, completava la sua grandissima competenza e la sua preparazione scientifica. Se n’è andato in punta di piedi, con la signorilità di sempre, con quel suo sorriso che metteva a suo agio anche le persone più semplici ed umili al suo cospetto! C’era sempre in questo grande personaggio della nostra specialità un senso di comprensione ed una capacità di aiutare gli altri a superare le difficoltà e le drammaticità anche di fronte alla diagnosi difficili che lo rendeva ammirevole a tutti. [...]
Italia-Cina. Grillo: “La salute è un elemento strategico del partenariato. La firma degli accordi di oggi ne è la piena conferma”
25 marzo 2019 - Siglati tre accordi in materia sanitaria da lungo tempo oggetto in corso di approfonditi negoziati bilaterali nei settori alimentari, veterinario e della salute. Il primo riguarda il nuovo Piano di Azione per il triennio 2019-21 in materia di cooperazione sanitaria tra i due Paesi. [...]
Le 15 società scientifiche aderenti al “Patto” si incontrano in Agenas
25 marzo 2019 - Si tratta delle società che hanno sottoscritto un protocollo di azioni comuni lo scorso luglio e che oggi suggellano il Patto in Agenas alla presenza dei sottosegretari alla Salute Luca Coletto e Armando Bartolazzi. [...]
Antibioticoresistenza. L’Italia cambia strategia, nasce “SPiNCAR” un sistema integrato per mettere in sicurezza tutte le strutture sanitarie
25 marzo 2019 - SPiNCAR sta per “Supporto al Piano Nazionale di Contrasto Antibioticoresistenza” ed è un sistema operativo del Servizio Sanitario Nazionale per lo sviluppo degli obiettivi fissati dal Piano Nazionale di Contrasto dell’Antimicrobico-Resistenza (Pncar) voluto dal Ministero della Salute. [...]
Autismo e depressione. Rischio a lungo termine aumenta se c’è stata esposizione fetale a infezioni materne
25 marzo 2019 - Un team di ricercatori USA ha studiato i dati dei registri svedesi delle nascite, per un totale di oltre 4 milioni di individui seguiti fino ai 41 anni. I ricercatori hanno scoperto una correlazione tra infezioni comuni delle madri, come quelle del tratto urinario, e aumento dell’incidenza dei casi di autismo e depressione nei figli. [...]
Allattamento al seno in caso di calamità naturali. Il documento del Ministero della Salute
25 marzo 2019 - Il Tavolo tecnico operativo interdisciplinare per la promozione dell’allattamento al seno TAS ha affrontato la problematica legata all’allattamento in occasione di calamità naturali e/o fenomeni di people displacement. [...]
Tumore cervice uterina. In Friuli Venezia Giulia adozione graduale del test HPV al posto del Pap test
25 marzo 2019 - Il nuovo test di screening per la prevenzione del carcinoma del collo dell’utero sarà offerto gratuitamente alle donne di età compresa tra i 30 e i 65 anni, affiancando la vaccinazione anti-HPV che è rivolta a ragazze e ragazzi nel 12° anno di età. Riccardi: “Contiamo di ridurre drasticamente la malattia”. [...]
Eterologa. Fondazione PMA: “A rischio dal 29 aprile in Italia, anche per i trattamenti in corso”. Lanciato appello al Ministero della Salute
25 marzo 2019 - A breve potrebbe non essere più possibile importare gameti ed effettuare la fecondazione eterologa in molti centri italiani preposti, una pratica che interessa oltre 6mila coppie ogni anno. La denuncia arriva dal Congresso nazionale della Fondazione PMA che si è svolto la settimana scorsa a Firenze. “Il Ministero richiede entro il 29 aprile i certificati di conformità. Molte strutture però non li hanno perché Regioni ed enti di vigilanza non hanno fatto le ispezioni necessarie”, ha affermato Gianni Baldini, direttore della Fondazione. [...]
Maggiore rischio complicanze nel parto in caso di eccessivo aumento di peso
25 marzo 2019 - Le donne che acquistano più peso rispetto a quello consigliato in gravidanza potrebbero avere maggiori probabilità di gravi complicanze durante il parto. A sostenerlo uno studio condotto su oltre mezzo milione di parti a New York City. In particolare, le donne che avevano preso più di 9 kg presentavano tassi più elevati di insufficienza cardiaca, ipertensione grave e necessità di una trasfusione o di ventilazione. [...]
Salute materna. Oms: “Perdere un bambino in gravidanza: ecco perché bisogna parlarne”
25 marzo 2019 - “Perdere un bambino durante la gravidanza a causa di un aborto spontaneo o per morte prematura del feto è ancora un argomento tabù in tutto il mondo, collegato a pregiudizi e sentimenti di colpa. Quando ciò accade, molte donne non ricevono cure appropriate e rispettose e non vengono aiutate a esprimere il loro dolore”. L'inchiesta dell’Organizzazione mondiale della sanità mette al centro le storie di donne di diversa provenienza geografica che hanno vissuto l’esperienza in prima persona. [...]
Punti nascita. Governo conferma intenzione di rivedere il Piano nazionale del 2010: “Forte denatalità consente di ridisegnare l’architettura della rete”
25 marzo 2019 - "Partendo dai dati dei flussi correnti, mediante analisi statistico epidemiologiche, si potranno infatti definire, con accettabile predittività, gli elementi utili sia a individuare i principali aspetti strutturali e organizzativi dei Punti nascita, sia ad identificare i parametri necessari per disegnare una rete di offerta ottimale per l’assistenza alle donne ed ai neonati". Così il ministro per i Rapporti con il Parlamento ha risposto alla Camera all'interrogazione di Lorenzin (Cp). [...]
Lettera della Presidente
Care colleghe, cari colleghi, nella NL troverete l’intervento del Ministro Fraccaro sui Punti nascita. Certamente la forte denatalità e la carenza dei medici sono argomenti che meritano una riflessione, ma mi preme segnalare alcuni aspetti. La denatalità è un problema sociale che coinvolge non solo l’Italia, anche se è uno dei Paesi maggiormente interessati, ma tutto il mondo occidentale e proseguirà nei prossimi decenni: urge non solo riflettere ma mettere in atto misure che consentano davvero una tutela della salute delle donne e della maternità. [...]
Tumori. Tra il 2003 e il 2014 incidenza e mortalità in calo. Meglio gli uomini che le donne e il Nord che il Sud. Ecco la mappa Regione per Regione e per tipo di cancro. Il rapporto Airtum
1 aprile 2019 - I numeri presentati a Trapani al 23° Congresso dell’Associazione Italiana dei Registri Tumori nella monografia ‘I tumori in Italia’. Trend 2003-2014 che presenta per la prima volta gli andamenti della patologia tumorale divisa per singole regioni. Sia in termini di incidenza che di mortalità, tuttavia, si registra una situazione nettamente migliore per gli uomini rispetto alle donne e tra le Regioni del Nord rispetto a quelle meridionali dove, per le donne, l'incidenza risulta addirittura in aumento e la mortalità è stabile. [...]
Seno denso. Più screening e diagnosi con leggi ad hoc. L’esempio Usa
1 aprile 2019 - Negli Usa alcuni Stati prevedono per legge che le donne con seno denso siano informate, e talora consigliate dal medico, a effettuare ulteriori esami e screening. Un gruppo di ricercatori del Connecticut ha avuto modo di constatare che l’obbligo di legge sta facendo aumentare i controlli e le diagnosi di tumore al seno. [...]
Sonno della mamma ed eczema del bambino non vanno d’accordo
1 aprile 2019 - Uno studio USA ha valutato oltre 11 mila coppie madre-figlio per una media di 11 anni, scoprendo una proporzione diretta tra la gravità della dermatite del bimbo e il numero di ore di “non sonno” della mamma. [...]
Linee d’indirizzo del Ministero Salute sull’assistenza in autonomia da parte delle ostetriche nelle gravidanze a basso rischio
1 aprile 2019 - L’obiettivo è quello di promuovere soluzioni organizzative che rispondano non solo a criteri di qualità e sicurezza ma garantiscano una maggiore continuità nell’assistenza in gravidanza, parto e puerperio, offrendo alla donna, debitamente informata, la possibilità di scelta del setting assistenziale. [...]
Fecondazione eterologa. Pronto per l’esame del Consiglio dei Ministri il Dpr di recepimento della normativa europea
1 aprile 2019 - La direttiva UE era stata recepita nell'ordinamento interno solo in maniera "parziale" a causa del divieto di procreazione eterologa stabilito dalla legge 40/2004. Ora, dopo che la Consulta ha riconosciuto l'illegittimità costituzionale di questa disposizione, il Governo rimette mano a tutta la normativa in materia di donazione di cellule e tessuti umani. Il provvedimento dovrebbe peraltro consentire di risolvere il contenzioso instauratori in materia con innanzi alla Corte di Giustizia UE. [...]
Antibiotici. Presi in gravidanza raddoppia il rischio di malattie infiammatorie croniche intestinali per il bambino
1 aprile 2019 - Lo rileva uno studio svedese secondo il quale l'esposizione agli antibiotici in fase gestazionale ha aumentato di quasi due volte il rischio di sviluppare una malattia infiammatoria cronica intestinale prima dei 6 anni di età, aumento che non si è invece verificato se l’esposizione è avvenuta in età infantile. [...]